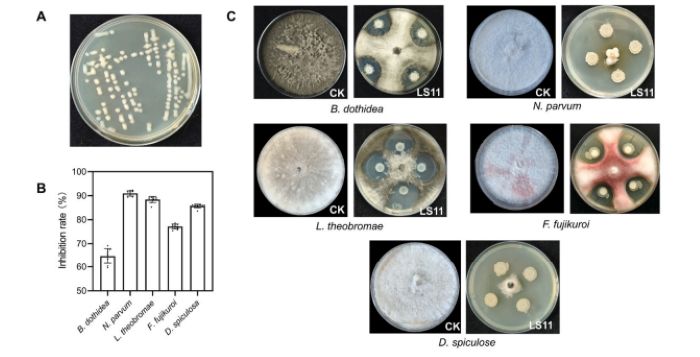
marciumi del kiwi

Indice
Non è una novità. La conservazione post-raccolta del kiwi è spesso compromessa da marciumi che possono compromettere la resa commerciale del frutto. Tra i principali responsabili figurano patogeni come Lasiodiplodia theobromae, Neofusicoccum parvum, Botryosphaeria dothidea, Diaporthe spiculosa e Fusarium fujikuroi. Per anni, la principale strategia di controllo è stata l’utilizzo di fungicidi tradizioni. Oggi, però, la crescente attenzione ai residui tossici e al rischio di resistenze nei patogeni sta accelerando la ricerca di soluzioni più sostenibili, orientate verso strategie di difesa “green”, come il biocontrollo.
Ed è proprio da questa esigenza che arriva una risposta promettente dalla ricerca scientifica. Un team di ricercatori cinesi ha infatti individuato un batterio “buono” che potrebbe diventare un alleato prezioso nella lotta contro i marciumi del kiwi. Si tratta di Bacillus subtilis, ceppo LS11, già noto per la sua capacità di inibire patogeni post-raccolta di frutti come pesche e ciliegie, grazie alla produzione di lipopeptidi, antibiotici naturali e composti volatili. In questo studio i ricercatori hanno approfondito il potenziale del ceppo Bacillus subtilis LS11 per valutarne l’efficacia come agente di biocontrollo e chiarirne i meccanismi d’azione specifici nella conservazione del kiwi.
Come è stato condotto lo studio
Per valutare il potenziale di Bacillus subtilis LS11 come strumento naturale contro i marciumi del kiwi, i ricercatori hanno messo a punto un approccio sperimentale integrato, capace di combinare prove di laboratorio, test applicativi sui frutti e analisi comparative. In una prima fase, l’attenzione si è concentrata sull’attività antifungina del batterio: la sua capacità di inibire la crescita dei principali patogeni è stata valutata in coltura e confrontata con campioni non trattati. Il passo successivo ha portato il batterio direttamente sul campo di prova: il brodo di fermentazione di LS11 è stato applicato su kiwi freschi, poi osservati nel tempo per misurare sia l’insorgenza dei marciumi sia le variazioni dei principali parametri di qualità, come consistenza della polpa, contenuto zuccherino e acidità.
In parallelo, l’impiego di tecniche avanzate di sequenziamento genomico e di analisi del DNA fungino ha permesso di identificare con precisione il ceppo batterico e di monitorare i cambiamenti nelle comunità microbiche associate ai frutti. A completare il quadro, un’analisi metabolomica non mirata ha ricostruito il profilo chimico dei kiwi, offrendo una visione d’insieme dei processi biologici attivati dal trattamento. Un ventaglio di metodologie diverse ma complementari, pensato per comprendere a fondo il ruolo di LS11 nella conservazione post-raccolta del kiwi.
Morfologia di LS11 su piastre LB (A) e analisi statistica (B) e immagini (C) dell’effetto inibitorio di LS11 su diversi batteri patogeni post-raccolta del kiwi. Fonte: ScienceDirect
Un batterio “alleato” contro i marciumi del kiwi
I test di laboratorio raccontano una storia decisamente promettente: Bacillus subtilis LS11 si è dimostrato capace di contrastare in modo efficace i principali funghi responsabili dei marciumi del kiwi dopo la raccolta. Il segreto della sua efficacia risiede nel patrimonio genetico del batterio, ricco di geni coinvolti nella produzione di sostanze naturali ad azione antifungina. Una vera e propria “dotazione chimica” che rende LS11 un alleato potente nel biocontrollo delle avversità. In particolare, il batterio ha mostrato un’elevata capacità di inibizione nei confronti di patogeni particolarmente aggressivi come Neofusicoccum parvum, Lasiodiplodia theobromae e Diaporthe spiculosa. Non tutti i funghi, però, rispondono allo stesso modo: le differenze osservate sono probabilmente legate alla struttura delle loro pareti cellulari e alla diversa sensibilità ai composti prodotti da LS11.
Quando applicato direttamente sui frutti, LS11 non si limita a ridurre l’incidenza del marciume, ma contribuisce anche a mantenere più a lungo la consistenza del kiwi. Un risultato di grande rilievo, soprattutto perché ottenuto senza alterare parametri chiave per il gusto e il valore nutrizionale, come contenuto zuccherino, acidità e vitamina C. L’effetto positivo sulla consistenza potrebbe essere collegato all’influenza del batterio sugli ormoni naturali del frutto, che regolano i processi di maturazione e rallentano il deterioramento dei tessuti. Ma non è tutto.
Difesa naturale del frutto
Il trattamento agisce anche sull’equilibrio dei microrganismi presenti sul kiwi: i funghi patogeni che colonizzano la superficie del frutto diminuiscono sensibilmente, mentre aumenta la diversità dei funghi interni, dando origine a un ecosistema microbico più stabile e meno favorevole allo sviluppo delle avversità. Una sorta di “scudo biologico” naturale, che rafforza le difese del frutto nel tempo. A spiegare questa efficacia contribuiscono anche le analisi chimiche del brodo di fermentazione di LS11, che hanno identificato ben 26 metaboliti biologicamente attivi. Tra questi spiccano antibiotici naturali come la natamicina e lipopeptidi come la surfactina, noti per la loro potente azione antifungina, insieme a composti con attività antiossidante, capaci di favorire la conservazione e la stabilità del frutto.
Lo studio evidenzia inoltre che LS11 esprime la massima efficacia a temperatura ambiente, mentre saranno necessari ulteriori approfondimenti per valutarne l’impiego nelle condizioni tipiche della conservazione commerciale, a basse temperature. Nel complesso, LS11 si conferma come una soluzione naturale ad alte prestazioni, capace di intervenire su più livelli: sopprime direttamente i patogeni, riequilibra la microflora associata al frutto e contribuisce a preservarne la qualità nel tempo.
Prospettive future: verso una conservazione post-raccolta sostenibile
Insomma, questo studio non fornisce solo il nome di un ceppo batterico efficace (LS11), ma propone una solida base teorica per una nuova concezione della conservazione della frutta. La strada verso l’applicazione commerciale appare ormai tracciata.
I prossimi passaggi riguarderanno la verifica dell’efficacia di LS11 nelle condizioni reali della catena del freddo (0–4 °C) e la sua integrazione con altre tecniche di conservazione già in uso. Intanto, questo studio rappresenta un riferimento tecnico di grande valore, aprendo la possibilità di estendere strategie di biocontrollo analoghe anche ad altri frutti. Un potenziale punto di svolta verso un’agricoltura e una filiera ortofrutticola più sicure, sostenibili e attente alla qualità finale del prodotto, dove la natura, ancora una volta, offre alcune delle risposte più eleganti alle sfide poste dall’uomo.
Federica Del Vecchio
© fruitjournal.com